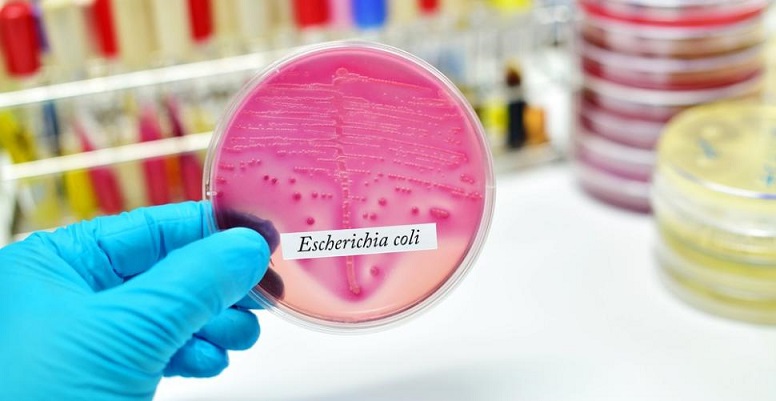

قضت الدائرة الاستئنافية ـ عقود النقل براً وبحراً وجواً بمحكمة الاستثمار والتجارة، بزيادة تعويض مسافر وأسرته تعرضا لضررين مادي وأدبي في مطار أوروبي،...
رئيس مجلس الإدارة : د. خالد بن ثاني آل ثاني

رئيس التحرير: جابر سالم الحرمي

مساحة إعلانية
مساحة إعلانية
تقارير وحوارات
4274
أمريكا تعلن تفشي بكتيريا الإشريكية القولونية في 4 ولايات.. 8 حقائق عن أعراضها ونصائح الصحة العالمية
ارتفع عدد الأشخاص المصابين ببكتيريا الإشريكية القولونية في الولايات المتحدة الأمريكية إلى 84 شخصاً بعد إعلان المراكز الأمريكية لمكافحة الأمراض والوقاية منها أمس تفشي البكتيريا في 4 ولايات في الغرب الأوسط من مصدر غير معروف أثر على 47 شخصاً آخرين.
وقالت رويترز إنه حتى يوم الأربعاء، تم نقل 38 شخصاً إلى المستشفى. وعلى الرغم من أن العديد من سلالات بكتيريا الإشريكية القولونية توجد في أمعاء الأشخاص والحيوانات الأصحاء وهي غير ضارة، فإن أنواعاً معينة يمكن أن تسبب تقلصات شديدة في الأمعاء وإسهالا دمويا وقيئ.
وقالت المراكز إنه من بين 62 شخصاً قابلتهم، تبين أن 52 تناولوا الطعام في مطاعم وينديز في الأسبوع السابق لبدء مرضهم، في حين قالت سلسلة مطاعم البرجر لرويترز في رسالة بالبريد الإلكتروني "نتعاون بشكل كامل مع سلطات الصحة العامة في تحقيقاتها الجارية بشأن تفشي الإشريكية القولونية على المستوى المحلي".
وتمثل الحالات الجديدة زيادة عن يوم الجمعة الماضي عندما بدأت المراكز الأمريكية تحقيقاً بعد إصابة 37 شخصاً في جميع أنحاء ميشيجان وأوهايو وإنديانا وبنسلفانيا. وقالت المراكز إن العديد منهم تناولوا شطائر مضاف لها الخس الروماني في سلسلة مطاعم وينديز قبل مرضهم.
ومع ذلك، لم تنصح المراكز بعدم تناول الطعام في مطاعم وينديز أو تطلب من الناس تجنب الخس الروماني لعدم التأكد بعد من السبب الدقيق لتفشي المرض.
وكإجراء احترازي أكدت الشركة المالكة لسلسلة المطاعم استبدال الخس في الشطائر في بعض المناطق المتضررة.
وقالت المراكز الأمريكية إن العدد الحقيقي للمرضى من المرجح أن يكون أعلى من المسجل، وقد لا يقتصر تفشي المرض على الولايات التي ظهرت بها حالات.
فما هي الإشريكية القولونية وكيف تنتقل وما هي أعراضها؟
تقول منظمة الصحة العالمية عبر موقعها في تقرير نُشر فبراير 2018، هناك حقائق رئيسية عن بكتيريا الإشريكية القولونية، هي:
1- الإشريكية القولونية (E. coli) هي جرثومة توجد عادة في الأمعاء الغليظة للكائنات ذات الدم الحار. ومعظم سلالات الإشريكية القولونية غير ضارة، ومع ذلك فيمكن لبعضها أن يسبب التسمم الغذائي الخطير.
الإشريكية القولونية (E. coli) المنتجة لذيفان الشيغا هي جرثومة يمكن أن تسبب مرضاً وخيماً منقولاً بالأغذية.
2- يتمثل المصدر الأول لفاشيات الإشريكية القولونية المنتجة لذيفان الشيغا في منتجات اللحم المفروم النيئة أو غير المطهوة جيداً، والحليب النيئ، والخضروات الملوثة بالبراز.
- وفي معظم الحالات يكون الاعتلال محدوداً ذاتياً، ولكنه قد يؤدي إلى مرض مهدد للحياة، بما في ذلك متلازمة انحلال الدم اليوريمي، ولاسيما في صغار الأطفال وكبار السن.
3- تتأثر الإشريكية القولونية المنتجة لذيفان الشيغا بالحرارة. فعند تحضير الطعام في المنزل تأكد من اتّباع ممارسات النظافة الغذائية الأساسية مثل "الطهو الجيد".
4 - تنتج هذه الإشريكية القولونية الذيفان المعروف باسم ذيفان الشيغا لأنه يشبه الذيفان الذي تنتجه جرثومة الشيغيلة الزحارية. ويمكن للإشريكية القولونية المنتجة لذيفان الشيغا أن تنمو في درجات حرارة تتراوح بين 7 درجات و50 درجة مئوية، وتبلغ درجة الحرارة المُثلى لنموها 37 درجة مئوية. وبعض أنواع الإشريكية القولونية المنتجة لذيفان الشيغا يمكنها أن تنمو في الأغذية الحمضية ذات الأس الهيدروجيني البالغ 4.4 على الأكثر، وفي الأغذية ذات النشاط المائي البالغ 0.95 كحد أدنى.
5 - يمكن القضاء على الإشريكية القولونية المنتجة لذيفان الشيغا بالطهو الجيد للأغذية حتى تصل درجة حرارة جميع أجزائها إلى 70 درجة مئوية أو أكثر. وتُعد الإشريكية القولونية المنتجة لذيفان الشيغا O157:H7 أهم الأنماط المصلية لهذه الإشريكية القولونية فيما يتعلق بالصحة العمومية؛ ومع ذلك فهناك أنماط مصلية أخرى ارتبطت في أحيان كثيرة بالحالات المتفرقة والفاشيات.
6- الأعراض
- تشمل أعراض المرض الذي تسببه الإشريكية القولونية المنتجة لذيفان الشيغا، المغص البطني والإسهال الذي قد يتطور في بعض الحالات إلى إسهال دموي (التهاب القولون النزفي).
- قد تحدث الحمى والقيء. وقد تتراوح فترة الحضانة ما بين 3 و8 أيام، وتستمر في المتوسط 3 أو 4 أيام.
- يتعافى معظم المرضى في غضون 10 أيام، ولكن في نسبة صغيرة من المرضى (ولاسيما صغار الأطفال وكبار السن)، قد تؤدي العدوى إلى مرض مهدد للحياة مثل متلازمة انحلال الدم اليوريمي. وتتمثل متلازمة انحلال الدم اليوريمي في الفشل الكلوي الحاد، وفقر الدم الانحلالي وقلة الصفيحات (انخفاض عدد الصفائح الدموية).
وتشير التقديرات إلى أن 10% من المرضى المصابين بعدوى الإشريكية القولونية المنتجة لذيفان الشيغا قد يصابون بمتلازمة انحلال الدم اليوريمي، ويتراوح معدل الإماتة في الحالات بين 3 و5%.
وفي العموم تُعد متلازمة انحلال الدم اليوريمي السبب الأكثر شيوعاً للفشل الكلوي الحاد بين صغار الأطفال. وقد تؤدي إلى مضاعفات عصبية (مثل النوبات والسكتة الدماغية والغيبوبة) في 25% من المرضى المصابين بمتلازمة انحلال الدم اليوريمي، وإلى عقابيل كلوية مزمنة في نحو 50% من الناجين، عادة ما تكون خفيفة.
وينبغي للأشخاص الذين يصابون بالإسهال الدموي أو المعص البطني الحاد أن يلتمسوا الرعاية الطبية. وقد تكون المضادات الحيوية جزءاً من علاج المرضى المصابين بالإشريكية القولونية المنتجة لذيفان الشيغا، ويحتمل أن تزيد من مخاطر تعرضهم لمتلازمة انحلال الدم اليوريمي لاحقاً.
المصادر وانتقال العدوى
تتعلق معظم المعلومات المتاحة عن الإشريكية القولونية المنتجة لذيفان الشيغا بالنمط المصلي O157:H7، نظراً لسهولة تمييزه من الناحية البيوكيميائية عن سلالات الإشريكية القولونية الأخرى.
- يبدو أن مستودع هذا الممرض يتمثل في المقام الأول في الأبقار. وفضلاً عن ذلك، فإن الحيوانات المجترة الأخرى مثل الغنم والماعز والأيائل تُعد مستودعات مهمة، واكتُشفت العدوى بين الثدييات الأخرى (مثل الخنازير والجياد والأرانب والكلاب والقطط) والطيور (مثل الدجاج والديوك الرومية).
- وتنتقل هذه الإشريكية القولونية O157:H7 إلى البشر في المقام الأول عن طريق استهلاك الأغذية الملوثة، مثل منتجات اللحوم المفرومة النيئة أو غير المطهوة جيداً، والحليب النيء.
- كما أن تلوث المياه والأغذية الأخرى بالبراز وانتقال التلوث من بعض الأغذية إلى أغذية أخرى أثناء تحضير الطعام (مثل لحم البقر ومنتجات اللحوم الأخرى، والأسطح وأدوات المطبخ الملوثة)، قد يؤديان أيضاً إلى العدوى. وتشمل الأمثلة عن الأغذية التي أدت إلى تفشي الإشريكية القولونية O157:H7 أقراص اللحم (هامبرغر) غير المطهوة جيداً، وأصابع اللحم المقدد والمملح (سالامي)، وعصير التفاح الطازج غير المبستر، واللبن الزبادي، والجبن المصنوع من الحليب النيئ.
- هناك عدد متزايد من الفاشيات المرتبطة باستهلاك الفاكهة والخضر (بما في ذلك البراعم والسبانخ والخس وسلطة الكرنب والسلطة)، التي قد يكون فيها التلوث ناجماً عن ملامسة روث الحيوانات المنزلية والبرية في إحدى مراحل الزراعة أو المناولة.
- تبين أن زيارة المزارع والأماكن الأخرى التي قد يخالط فيها الجمهور العام حيوانات المزارع على نحو مباشر أو غير مباشر، تُعد من عوامل الخطر المهمة للعدوى بالإشريكية القولونية المنتجة لذيفان الشيغا.
7- الوقاية
تتطلب الوقاية من العدوى اتخاذ تدابير المكافحة في جميع مراحل السلسلة الغذائية، بدءاً من الإنتاج الزراعي في المزرعة ووصولاً إلى تجهيز الأغذية وتصنيعها وتحضيرها في المنشآت التجارية والمطابخ المنزلية.
8- المنزل
تماثل تدابير الوقاية من العدوى بالإشريكية القولونية O157:H7 التدابير التي يوصى بها للوقاية من الأمراض الأخرى المنقولة بالأغذية. ومن شأن الممارسات الجيدة لنظافة الأغذية الواردة في "الوصايا الخمس لضمان مأمونية الغذاء" الصادرة عن المنظمة، أن تقي من انتقال الممْرضات المسؤولة عن العديد من الأمراض المنقولة بالأغذية، وأن تحمي أيضاً من الأمراض المنقولة بالأغذية الناجمة عن الإشريكية القولونية المنتجة لذيفان الشيغا.
والوصايا الخمس لضمان مأمونية الغذاء هي:
1- الحفاظ على النظافة.
2- فصل الأغذية النيئة عن الأغذية المطهوة.
3- طهو الأغذية جيداً.
4- الحفاظ على الأغذية في درجات حرارة مأمونة.
5- استخدام المياه والمواد الخام المأمونة.
اقرأ أيضاً
أخبار ذات صلة
مساحة إعلانية
مساحة إعلانية
الأكثر مشاهدة

أكدت وزارة الداخلية أهمية الحرصعلى تركيب كاميرات المراقبة الأمنية من الشركات المُرخّصة والمعتمدة لدى إدارة النظم الأمنية، بالإدارة العامة للاتصالات ونظم المعلومات بوزارة...
19660
| 28 يونيو 2026

أوضحت وزارة الداخلية أنه في إطار إجراءات التدقيق والمتابعة الروتينية للوسائط البحرية والتي تضطلع بها الإدارة العامة لأمن السواحل والحدود، تبين تأخر إحدى...
15226
| 28 يونيو 2026

يترقب طلاب الشهادة الثانوية العامة في قطر إعلان نتائجهم خلال الأيام القليلة المقبلة، وذلك بعد انتهاء الاختبارات يوم الأحد الماضي، وسط مؤشرات أولية...
12540
| 29 يونيو 2026
مساحة إعلانية
مساحة إعلانية
الشرق الإقتصادي

تراجعت أسعار الذهب اليوم بعد أن سجلت أدنى مستوى لها في سبعة أشهر خلال الجلسة السابقة، تحت ضغط ارتفاع عوائد سندات الخزانة الأمريكية،...
930
| 01 يوليو 2026

ارتفعت أسعار النفط 0.7 بالمئة في بداية تعاملات اليوم. وارتفع خام برنت 50 سنتا أو 0.69 بالمئة إلى 73.45 دولار للبرميل، بينما صعد...
74
| 01 يوليو 2026

فيما يلي بيان بأسعار بعض العملات الأجنبية مقابل الريال القطري كما وردت من بنك قطر الوطني اليوم: العملة الشراء البيع ريال سعودي 0.96200...
180
| 01 يوليو 2026

أعلن بنك لشا عن تنفيذ استثمار غير مباشر من خلال صندوق استثماري يديره البنك في صندوق CVC-PE Global Private Equity، وهو صندوق فرعي...
60
| 01 يوليو 2026
مساحة إعلانية

حمل تطبيق الشرق
تابع الأخبار المحلية والعالمية من خلال تطبيقات الجوال المتاحة على متجر جوجل ومتجر آبل
آخر المقالات
-
الكرة القطرية... المشروع أكبر من بطولة
نايف خالد الشرشني
-
محطة جديدة في مسيرة تطوير قطاع الفضاء

رأي الشرق
-
لا تحمل الحياة على كتفيك

موزا محمد الكواري
-
متى ترحل؟

المهندس إبراهيم بن هاشم السادة
الأكثر رواجاً
- 1 التعليم تحدد موعد الإعلان عن نتائج الثانوية العامة في قطر
حددت وزارة التربية والتعليم موعد الإعلان عن نتائج الشهادة الثانوية العامة للعام الدراسي 2025-2026م (الدور الأول) إلكترونيًّا . وأوضحت الوزارة عبر حسابها بمنصة...
5782
| 30 يونيو 2026
- 2 350 ألف ريال تعويضاً لمصابة في حادث مروري
-المحامي عبدالله الهاجري: التعويض يقدر بمقدار الضرر المباشر الذي أحدثه الخطأ أيدت الدوائر الاستئنافية بمحكمة الاستثمار والتجارة حكم أول درجة بتغريم سائق تسبب...
5164
| 28 يونيو 2026
- 3 بدرية كافود: 3 إلى 5 ملايين ريال تكلفة الفيلا
-اشتراطات البلدية الجديدة أعطتنا مرونة في التصميم أكدت المهندسة بدرية كافود أن الاشتراطات الجديدة للفلل والقصور الصادرة عن وزارة البلدية، لا تؤثر على...
4260
| 30 يونيو 2026









